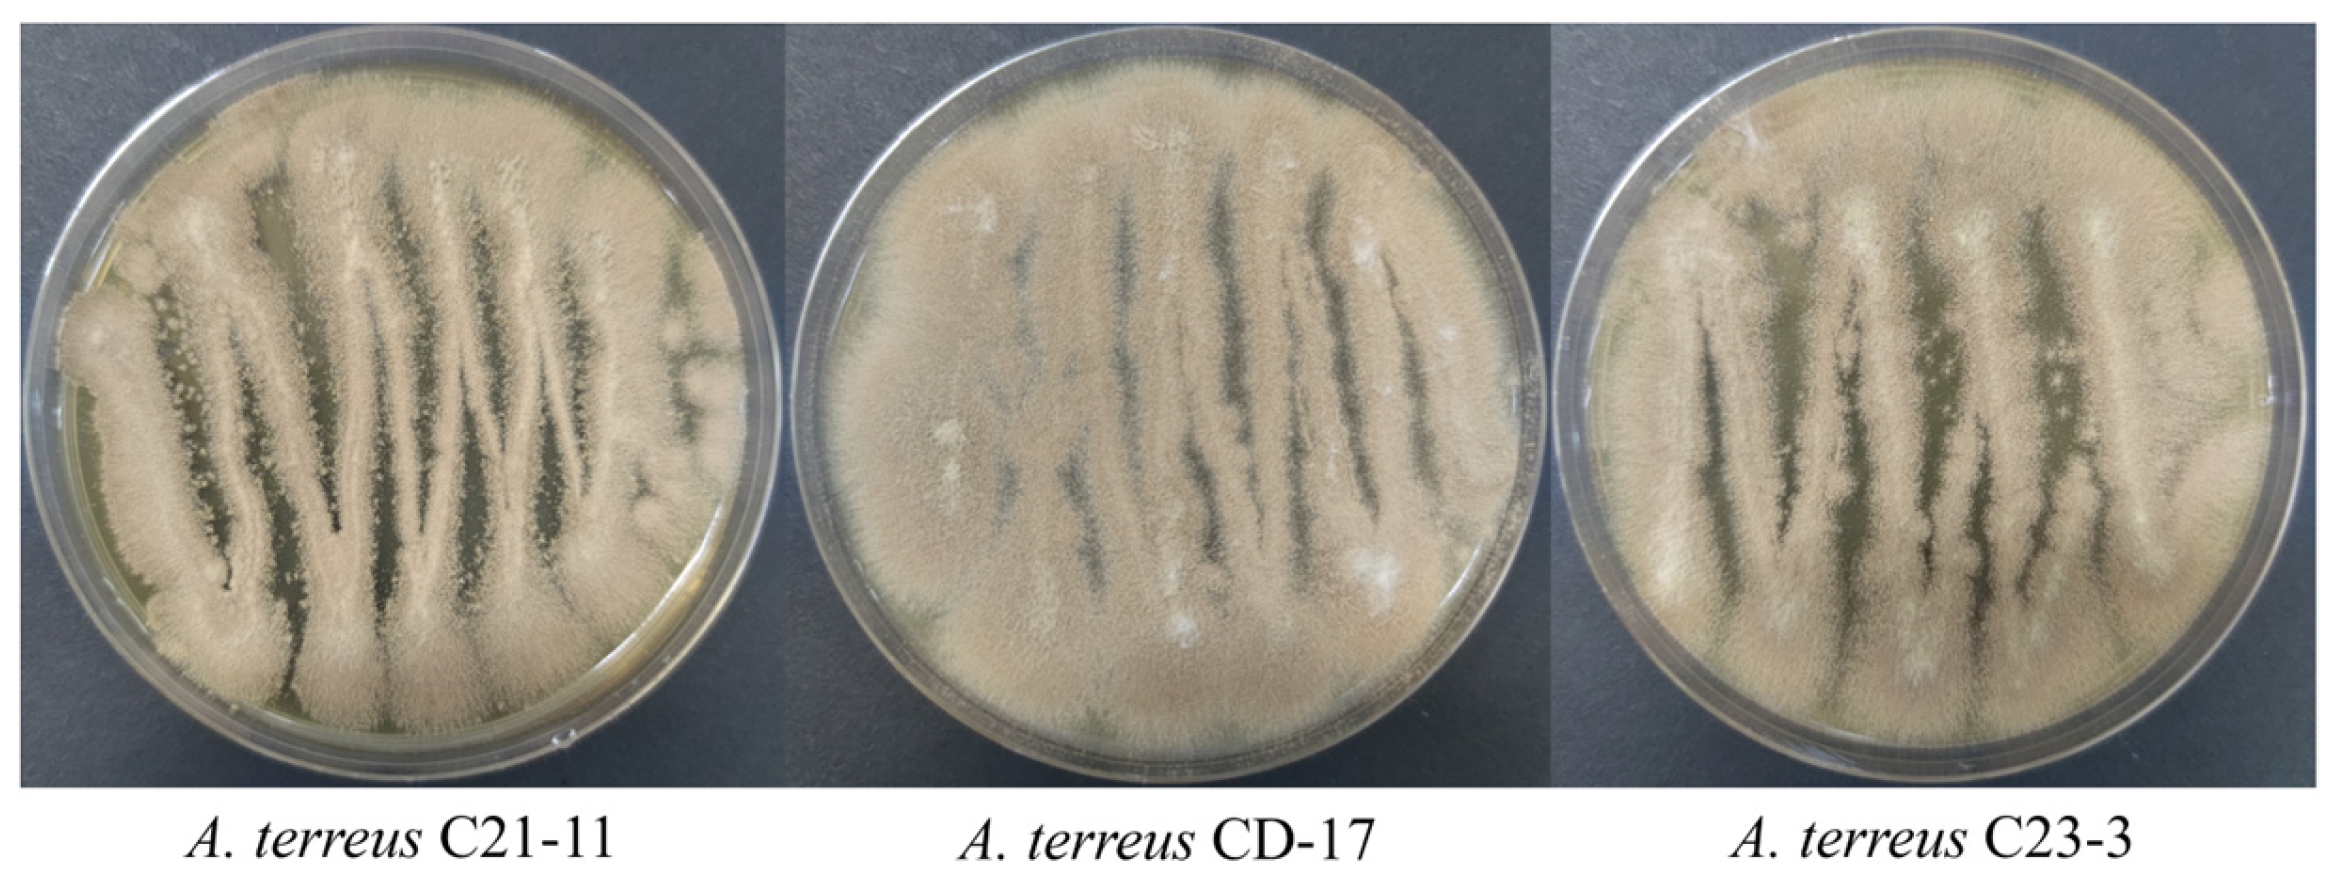

Exploring the Anti-Alzheimer’s Disease Potential of Aspergillus terreus C23-3 Through Genomic Insights, Metabolomic Analysis, and Molecular Docking
Abstract
1. Introduction
2. Materials and Methods
2.1. Fungal Fermentation and Secondary Metabolite Analysis
2.2. Strain Sample Preparation for Sequencing
2.3. Genome Sequencing
2.4. BGC Annotation
2.5. Phylogenetic Analysis
2.6. Molecular Network
- (1)
- A total of 10 µL of the sample was injected and eluted with a gradient of H2O containing 0.1% HCOOH and ACN (containing 0.1% HCOOH) with a gradient of 30% ACN for 0.5 min, 30–90% ACN for 7.5 min, 90% ACN 3 min, 90–30% ACN for 0.1 min, or 30% ACN for 3.9 min, and a flow rate of 0.3 mL/min on an Orbitrap Fusion Lumos (Thermo Fisher Scientific, Waltham, MA, USA) and a C18 column (Thermo Fisher Scientific-packed Hypersil GOLD, 1.9 µm, 2.1 × 100 mm). Mass spectra were recorded in positive ESI mode (m/z 50–1500). The obtained raw data were converted into mzXML format and uploaded to GNPS for molecular network construction, and the obtained results were visualized using the software Cytoscape 3.7.2.
- (2)
- Acquity UHPLC DAD Xevo G2-XS Q-Tof liquid chromatography–mass spectrometry instrument (Waters, Milford, MA, USA) was used with an ACN (containing 0.1% HCOOH)/H2O (containing 0.1% HCOOH) gradient (30% ACN for 0.5 min, 30–90% ACN for 4.5 min, 90% ACN 3 min, 90–30% ACN for 0.2 min, 30% ACN for 1.3 min) and a flow rate of 0.3 mL/min on a Waters ACQUITY UPLC BEH RP18 column (2.1 × 50 mm, 1.7 µm). Mass spectra were recorded in positive ESI mode (m/z 50–1500). The obtained raw data were converted into abf format and the chemical composition was analyzed using MS-DIAL.
2.7. Molecular Docking
2.8. In Silico Prediction of ADMET and Drug-Likeness Properties
3. Results
3.1. Aspergillus terreus Producer Screening
3.2. Genomic Profile
3.3. BGC Prediction
3.4. Metabolomic Analysis
3.5. Molecular Docking Analysis
3.6. ADMET Prediction
4. Discussion
5. Conclusions
Supplementary Materials
Author Contributions
Funding
Institutional Review Board Statement
Informed Consent Statement
Data Availability Statement
Acknowledgments
Conflicts of Interest
Abbreviations
| AD | Alzheimer’s disease |
| BGCs | Biosynthetic gene clusters |
| LC-MS | Liquid chromatography coupled with mass spectrometry |
| AChE | Acetylcholinesterase |
| CDK5/p25 | Cyclin-dependent kinase 5-p25 complex |
| GSK-3β | Glycogen synthase kinase-3β |
| MAO-B | Monoamine oxidase-B |
| Aβ | β-amyloid |
| AβOs | Aβ oligomers |
| DMAs | Disease-modifying agents |
| SMs | Secondary metabolites |
| IL-1β | Interleukin-1 β |
| iNOS | Inducible nitric oxide synthase |
| COX-2 | Cyclooxygenase-2 |
| NF-κB | Nuclear factor kappa-B |
| LPS | Lipopolysaccharide |
| MAPK | Mitogen-activated protein kinase |
| MS | Mass spectrometry |
| GNPS | Global natural product social molecular networking |
| EA | Ethyl acetate |
| MeOH | Methanol |
| DCM | Dichloromethane |
| TLC | Thin-layer chromatography |
| ROI | Rectangular region of interest |
| ACN | Acetonitrile |
| PDA | Potato dextrose agar |
| PDB | Potato dextrose broth |
| CCS | Circular consensus sequence |
| HMM | Hidden Markov model |
| PKS | Polyketide synthase |
| NRPS | Non-ribosomal peptide synthetase |
| CDS | Coding sequence |
| SAM | S-adenosylmethionine |
| BPC | Base peak chromatogram |
| HIA | Human intestinal absorption |
| BBB | Blood–brain barrier |
| OSMAC | One strain many compounds |
| GNP | Gold nanoparticle |
| AAIs | Aβ aggregation inhibitors |
| nAChR | Nicotinic acetylcholine receptor |
| APP | Amyloid precursor protein |
| IDE | Insulin-degrading enzyme |
References
- Safiri, S.; Jolfayi, A.G.; Fazlollahi, A.; Morsali, S.; Sarkesh, A.; Sorkhabi, A.D.; Golabi, B.; Aletaha, R.; Asghari, K.M.; Hamidi, S.; et al. Alzheimer’s disease: A comprehensive review of epidemiology, risk factors, symptoms diagnosis, management, caregiving, advanced treatments and associated challenges. Front. Med. 2024, 11, 1474043. [Google Scholar] [CrossRef]
- Ballinger, E.C.; Ananth, M.; Talmage, D.A.; Role, L.W. Basal forebrain cholinergic circuits and signaling in cognition and cognitive decline. Neuron 2016, 91, 1199–1218. [Google Scholar] [CrossRef]
- Andronie-Cioara, F.L.; Ardelean, A.I.; Nistor-Cseppento, C.D.; Jurcau, A.; Jurcau, M.C.; Pascalau, N.; Marcu, F. Molecular mechanisms of neuroinflammation in aging and Alzheimer’s disease progression. Int. J. Mol. Sci. 2023, 24, 1869. [Google Scholar] [CrossRef]
- Ballatore, C.; Lee, V.M.Y.; Trojanowski, J.Q. Tau-mediated neurodegeneration in Alzheimer’s disease and related disorders. Nat. Rev. Neurosci. 2007, 8, 663–672. [Google Scholar] [CrossRef]
- Hampel, H.; Hardy, J.; Blennow, K.; Chen, C.; Perry, G.; Kim, S.H.; Villemagne, V.L.; Aisen, P.; Vendruscolo, M.; Iwatsubo, T.; et al. The amyloid-β pathway in Alzheimer’s disease. Mol. Psychiatr. 2021, 26, 5481–5503. [Google Scholar] [CrossRef]
- Gonçalves, P.B.; Sodero, A.C.R.; Cordeiro, Y. Natural products targeting amyloid-β oligomer neurotoxicity in Alzheimer’s disease. Eur. J. Med. Chem. 2024, 276, 116684. [Google Scholar] [CrossRef] [PubMed]
- Srivastava, S.; Ahmad, R.; Khare, S.K. Alzheimer’s disease and its treatment by different approaches: A review. Eur. J. Med. Chem. 2021, 216, 113320. [Google Scholar] [CrossRef] [PubMed]
- Zheng, R.H.; Li, S.J.; Zhang, X.; Zhao, C.Q. Biological activities of some new secondary metabolites isolated from endophytic fungi: A review study. Int. J. Mol. Sci. 2021, 22, 959. [Google Scholar] [CrossRef] [PubMed]
- Keller, N.P. Fungal secondary metabolism: Regulation, function and drug discovery. Nat. Rev. Microbiol. 2019, 17, 167–180. [Google Scholar] [CrossRef]
- Yang, W.C.; Tian, S.R.; Du, Y.F.; Zeng, X.L.; Liang, J.J.; Lan, W.J.; Li, H. Genome mining of the marine-derived fungus Trichoderma erinaceum F1-1 unearths bergamotene-type sesquiterpenoids. J. Nat. Prod. 2024, 87, 2746–2756. [Google Scholar] [CrossRef]
- Feng, R.Y.; Dai, Q.; Ma, M.N.; Zhao, S.; Wang, Z.J.; Wang, H.M.; Zhang, Y.M.; Huo, L.J.; Yan, F. Discovery of ureido-containing alteropeptilides and intramolecular cyclized alteramides in Pseudoalteromonas flavipulchra S16 by promoter engineering of cryptic biosynthetic gene clusters. J. Nat. Prod. 2024, 87, 2801–2809. [Google Scholar] [CrossRef] [PubMed]
- Karthikeyan, A.; Joseph, A.; Nair, B.G. Promising bioactive compounds from the marine environment and their potential effects on various diseases. J. Genet. Eng. Biotechn. 2022, 20, 14. [Google Scholar] [CrossRef] [PubMed]
- Wang, H.N.; Sun, S.S.; Liu, M.Z.; Yan, M.C.; Liu, Y.F.; Zhu, Z.; Zhang, Z. Natural bioactive compounds from marine fungi (2017–2020). J. Asian Nat. Prod. Res. 2022, 24, 203–230. [Google Scholar] [CrossRef] [PubMed]
- Orfali, R.; Aboseada, M.A.; Abdel-Wahab, N.M.; Hassan, H.M.; Perveen, S.; Ameen, F.; Alturki, E.; Abdelmohsen, U.R. Recent updates on the bioactive compounds of the marine-derived genus Aspergillus. RSC Adv. 2021, 11, 17116–17150. [Google Scholar] [CrossRef]
- Zhang, Y.Y.; Zhang, Y.; Yao, Y.B.; Lei, X.L.; Qian, Z.J. Butyrolactone-I from coral-derived fungus Aspergillus terreus attenuates neuro-inflammatory response via suppression of NF-κB pathway in BV-2 Cells. Mar. Drugs 2018, 16, 202. [Google Scholar] [CrossRef]
- Nie, Y.Y.; Yang, J.M.; Zhou, L.J.; Yang, Z.Y.; Liang, J.Y.; Liu, Y.Y.; Ma, X.X.; Qian, Z.J.; Hong, P.Z.; Kalueff, A.; et al. Marine fungal metabolite butyrolactone I prevents cognitive deficits by relieving inflammation and intestinal microbiota imbalance on aluminum trichloride-injured zebrafish. J. Neuroinflamm. 2022, 19, 39. [Google Scholar] [CrossRef]
- Chen, M.Q.; Liang, J.Y.; Liu, Y.; Liu, Y.Y.; Zhou, C.X.; Hong, P.Z.; Zhang, Y.; Qian, Z.J. The mechanism of two benzaldehydes from Aspergillus terreus C23-3 improve neuroinflammatory and neuronal damage to delay the progression of Alzheimer’s disease. Int. J. Mol. Sci. 2023, 24, 905. [Google Scholar] [CrossRef]
- Chen, M.Q. Study on Mechanism of Compounds Derived from Marine Fungi Aspergillus terreus C23-3 Improve the Progression of Alzheimer’s Disease. Master’s Thesis, Guangdong Ocean University, Zhanjiang, China, 2023. [Google Scholar]
- Salins, P.; Shawesh, S.; He, Y.; Dibrov, A.; Kashour, T.; Arthur, G.; Amara, F. Lovastatin protects human neurons against Aβ-induced toxicity and causes activation of β-catenin-TCF/LEF signaling. Neurosci. Lett. 2007, 412, 211–216. [Google Scholar] [CrossRef]
- Arvanov, V.L.; Ling, K.H.; Chen, R.C.; Tsai, M.C. Effects of territrem-B on cholinergic responses of snail neuron. Neurosci. Lett. 1993, 152, 69–71. [Google Scholar] [CrossRef]
- Tsugawa, H.; Cajka, T.; Kind, T.; Ma, Y.; Higgins, B.; Ikeda, K.; Kanazawa, M.; VanderGheynst, J.; Fiehn, O.; Arita, M. MS-DIAL: Data-independent MS/MS deconvolution for comprehensive metabolome analysis. Nat. Methods 2015, 12, 523–526. [Google Scholar] [CrossRef]
- Hautbergue, T.; Jamin, E.L.; Debrauwer, L.; Puel, O.; Oswald, I.P. From genomics to metabolomics, moving toward an integrated strategy for the discovery of fungal secondary metabolites. Nat. Prod. Rep. 2018, 35, 147–173. [Google Scholar] [CrossRef] [PubMed]
- Wang, M.X.; Carver, J.J.; Phelan, V.V.; Sanchez, L.M.; Garg, N.; Peng, Y.; Nguyen, D.D.; Watrous, J.; Kapono, C.A.; Luzzatto-Knaan, T.; et al. Sharing and community curation of mass spectrometry data with global natural products social molecular networking. Nat. Biotechnol. 2016, 34, 828–837. [Google Scholar] [CrossRef]
- Oppong-Danquah, E.; Parrot, D.; Blümel, M.; Labes, A.; Tasdemir, D. Molecular networking-based metabolome and bioactivity analyses of marine-adapted fungi co-cultivated with phytopathogens. Front. Microbiol. 2018, 9, 2072. [Google Scholar] [CrossRef] [PubMed]
- Borkunov, G.V.; Kirichuk, N.N.; Chausova, V.E.; Popov, R.S.; Zhuravleva, O.I.; Chingizova, E.A.; Yurchenko, E.A.; Isaeva, M.P.; Yurchenko, A.N. Differences in metabolite profiles and bioactivities of intra-strain variants of marine fungus Penicillium antarcticum KMM 4668. Metabolites 2025, 15, 77. [Google Scholar] [CrossRef] [PubMed]
- Chen, Y.X.; Chen, Y.S.; Shi, C.M.; Huang, Z.B.; Zhang, Y.; Li, S.K.; Li, Y.; Ye, J.; Yu, C.; Li, Z.; et al. SOAPnuke: A mapreduce acceleration-supported software for integrated quality control and preprocessing of high-throughput sequencing data. Gigascience 2018, 7, gix120. [Google Scholar] [CrossRef]
- Korlach, J.; Bjornson, K.P.; Chaudhuri, B.P.; Cicero, R.L.; Flusberg, B.A.; Gray, J.J.; Holden, D.; Saxena, R.; Wegener, J.; Turner, S.W. Real-time DNA sequencing from single polymerase molecules. In Methods in Enzymology; Walter, N.G., Ed.; Elsevier Academic Press Inc: San Diego, CA, USA, 2010; Volume 472, pp. 431–455. [Google Scholar]
- Kim, K.E.; Peluso, P.; Babayan, P.; Yeadon, P.J.; Yu, C.; Fisher, W.W.; Chin, C.S.; Rapicavoli, N.A.; Rank, D.R.; Li, J.; et al. Long-read, whole-genome shotgun sequence data for five model organisms. Sci. Data 2014, 1, 140045. [Google Scholar] [CrossRef]
- Utturkar, S.M.; Klingeman, D.M.; Land, M.L.; Schadt, C.W.; Doktycz, M.J.; Pelletier, D.A.; Brown, S.D. Evaluation and validation of de novo and hybrid assembly techniques to derive high-quality genome sequences. Bioinformatics 2014, 30, 2709–2716. [Google Scholar] [CrossRef]
- Blin, K.; Shaw, S.; Augustijn, H.E.; Reitz, Z.L.; Biermann, F.; Alanjary, M.; Fetter, A.; Terlouw, B.R.; Metcalf, W.W.; Helfrich, E.J.N.; et al. AntiSMASH 7.0: New and improved predictions for detection, regulation, chemical structures and visualisation. Nucleic Acids Res. 2023, 51, W46–W50. [Google Scholar] [CrossRef]
- Tamura, K.; Stecher, G.; Kumar, S. MEGA11 molecular evolutionary genetics analysis version 11. Mol. Biol. Evol. 2021, 38, 3022–3027. [Google Scholar] [CrossRef]
- van den Belt, M.; Gilchrist, C.; Booth, T.J.; Chooi, Y.H.; Medema, M.H.; Alanjary, M. CAGECAT: The comparative gene cluster analysis toolbox for rapid search and visualisation of homologous gene clusters. BMC Bioinform. 2023, 24, 181. [Google Scholar] [CrossRef]
- Trott, O.; Olson, A.J. Software news and update autodock vina: Improving the speed and accuracy of docking with a new scoring function, efficient optimization, and multithreading. J. Comput. Chem. 2010, 31, 455–461. [Google Scholar] [CrossRef]
- Fu, L.; Shi, S.H.; Yi, J.C.; Wang, N.N.; He, Y.H.; Wu, Z.X.; Peng, J.F.; Deng, Y.C.; Wang, W.X.; Wu, C.K.; et al. ADMETlab 3.0: An updated comprehensive online ADMET prediction platform enhanced with broader coverage, improved performance, API functionality and decision support. Nucleic Acids Res. 2024, 52, W422–W431. [Google Scholar] [CrossRef] [PubMed]
- Guo, C.J.; Knox, B.P.; Sanchez, J.F.; Chiang, Y.M.; Bruno, K.S.; Wang, C.C. Application of an efficient gene targeting system linking secondary metabolites to their biosynthetic genes in Aspergillus terreus. Org. Lett. 2013, 15, 3562–3565. [Google Scholar] [CrossRef] [PubMed]
- Guo, C.J.; Sun, W.W.; Bruno, K.S.; Oakley, B.R.; Keller, N.P.; Wang, C.C. Spatial regulation of a common precursor from two distinct genes generates metabolite diversity. Chem. Sci. 2015, 6, 5913–5921. [Google Scholar] [CrossRef]
- Afiyatullov, S.S.; Leshchenko, E.V.; Sobolevskaya, M.P.; Gerasimenko, A.V.; Khudyakova, Y.V.; Kirichuk, N.N.; Mikhailov, V.V. New 3-[2’(R)-hydroxybutyl]-7-hydroxyphthalide from marine isolate of the fungus Penicillium claviforme. Chem. Nat. Compd. 2015, 51, 111–115. [Google Scholar] [CrossRef]
- Chiang, Y.M.; Szewczyk, E.; Davidson, A.D.; Keller, N.; Oakley, B.R.; Wang, C.C. A gene cluster containing two fungal polyketide synthases encodes the biosynthetic pathway for a polyketide, asperfuranone, in Aspergillus nidulans. J. Am. Chem. Soc. 2009, 131, 2965–2970. [Google Scholar] [CrossRef]
- Ellestad, G.A.; Evans, R.H., Jr.; Kunstmann, M.P. Some new terpenoid metabolites from an unidentified fusarium species. Tetrahedron 1969, 25, 1323–1334. [Google Scholar] [CrossRef]
- Zhang, P.; Bao, B.; Dang, H.T.; Hong, J.; Lee, H.J.; Yoo, E.S.; Bae, K.S.; Jung, J.H. Anti-inflammatory sesquiterpenoids from a sponge-derived fungus Acremonium sp. J. Nat. Prod. 2009, 72, 270–275. [Google Scholar] [CrossRef]
- Gui, R.Y.; Xu, L.; Kuang, Y.; Chung, I.M.; Qin, J.C.; Liu, L.; Yang, S.X.; Zhao, L.C. Chaetominine, (+)-alantrypinone, questin, isorhodoptilometrin, and 4-hydroxybenzaldehyde produced by the endophytic fungus Aspergillus sp. YL-6 inhibit wheat (Triticum aestivum) and radish (Raphanus sativus) germination. J. Plant Interact. 2015, 10, 87–92. [Google Scholar]
- Kittiwan, S.; Sasiphimol, S.; Phongphan, J.; Pakin, N.; Audomsak, C.; Nuttika, S.; Wiyada, M.; Thanaset, S.; Sarawut, T.; Pairot, M.; et al. Antiproliferative polyketides from fungus Xylaria cf. Longipes SWUF08-81 in different culture media. Nat. Prod. Bioprospect. 2024, 14, 6. [Google Scholar]
- Li, Y.; Li, X.; Lee, U.; Kang, J.S.; Choi, H.D.; Son, B.W. A new radical scavenging anthracene glycoside, asperflavin ribofuranoside, and polyketides from a marine isolate of the fungus Microsporum. Chem. Pharm. Bull. 2006, 54, 882–883. [Google Scholar] [CrossRef]
- Chiang, C.C.; Huang, T.N.; Lin, Y.W.; Chen, K.H.; Chiang, B.H. Enhancement of 4-acetylantroquinonol B production by supplementation of its precursor during submerged fermentation of Antrodia cinnamomea. J. Agric. Food Chem. 2013, 61, 9160–9165. [Google Scholar] [CrossRef]
- Haritakun, R.; Rachtawee, P.; Chanthaket, R.; Boonyuen, N.; Isaka, M. Butyrolactones from the fungus Aspergillus terreus BCC 4651. Chem. Pharm. Bull. 2010, 58, 1545–1548. [Google Scholar] [CrossRef]
- Pathak, C.; Kabra, U.D. A comprehensive review of multi-target directed ligands in the treatment of Alzheimer’s disease. Bioorganic Chem. 2024, 144, 107152. [Google Scholar] [CrossRef]
- Zeb, A.; Kim, D.; Alam, S.I.; Son, M.; Kumar, R.; Rampogu, S.; Parameswaran, S.; Shelake, R.M.; Rana, R.M.; Parate, S.; et al. Computational simulations identify pyrrolidine-2,3-dione derivatives as novel inhibitors of Cdk5/p25 complex to attenuate Alzheimer’s pathology. J. Clin. Med. 2019, 8, 746. [Google Scholar] [CrossRef]
- Muck-Seler, D.; Presecki, P.; Mimica, N.; Mustapic, M.; Pivac, N.; Babic, A.; Nedic, G.; Folnegovic-Smalc, V. Platelet serotonin concentration and monoamine oxidase type B activity in female patients in early, middle and late phase of Alzheimer’s disease. Prog. Neuro-Psychopharmacol. Biol. Psychiatry 2009, 33, 1226–1231. [Google Scholar] [CrossRef]
- Behl, T.; Kaur, D.; Sehgal, A.; Singh, S.; Sharma, N.; Zengin, G.; Andronie-Cioara, F.L.; Toma, M.M.; Bungau, S.; Bumbu, A.G. Role of monoamine oxidase activity in Alzheimer’s disease: An insight into the therapeutic potential of inhibitors. Molecules 2021, 26, 3724. [Google Scholar] [CrossRef]
- Jordaan, M.A.; Ebenezer, O.; Damoyi, N.; Shapi, M. Virtual screening, molecular docking studies and DFT calculations of FDA approved compounds similar to the non-nucleoside reverse transcriptase inhibitor (NNRTI) efavirenz. Heliyon 2020, 6, e04642. [Google Scholar] [CrossRef] [PubMed]
- Lipinski, C.A.; Lombardo, F.; Dominy, B.W.; Feeney, P.J. Experimental and computational approaches to estimate solubility and permeability in drug discovery and development settings. Adv. Drug Deliv. Rev. 2001, 46, 3–26. [Google Scholar] [CrossRef] [PubMed]
- Hughes, J.D.; Blagg, J.; Price, D.A.; Bailey, S.; DeCrescenzo, G.A.; Devraj, R.V.; Ellsworth, E.; Fobian, Y.M.; Gibbs, M.E.; Gilles, R.W.; et al. Physiochemical drug properties associated with in vivo toxicological outcomes. Bioorg. Med. Chem. Lett. 2008, 18, 4872–4875. [Google Scholar] [CrossRef] [PubMed]
- Johnson, T.W.; Dress, K.R.; Edwards, M. Using the golden triangle to optimize clearance and oral absorption. Bioorg. Med. Chem. Lett. 2009, 19, 5560–5564. [Google Scholar] [CrossRef]
- Nie, Y.Y.; Yang, W.C.; Liu, Y.Y.; Yang, J.M.; Lei, X.L.; Gerwick, W.H.; Zhang, Y. Acetylcholinesterase inhibitors and antioxidants mining from marine fungi: Bioassays, bioactivity coupled LC-MS/MS analyses and molecular networking. Mar. Life Sci. Technol. 2020, 2, 386–397. [Google Scholar] [CrossRef]
- Wang, Y.; Glukhov, E.; He, Y.F.; Liu, Y.Y.; Zhou, L.J.; Ma, X.X.; Hu, X.Q.; Hong, P.Z.; Gerwick, W.H.; Zhang, Y. Secondary metabolite variation and bioactivities of two marine Aspergillus strains in static co-culture investigated by molecular network analysis and multiple database mining based on LC-PDA-MS/MS. Antibiotics 2022, 11, 513. [Google Scholar] [CrossRef] [PubMed]
- Qi, J.F.; Chen, C.Y.; He, Y.J.; Wang, Y. Genomic analysis and antimicrobial components of M7, an Aspergillus terreus strain derived from the south China sea. J. Fungi 2022, 8, 1051. [Google Scholar] [CrossRef] [PubMed]
- Du, X.Y.; Li, H.H.; Qi, J.F.; Chen, C.Y.; Lu, Y.Y.; Wang, Y. Genome mining of secondary metabolites from a marine-derived Aspergillus terreus B12. Arch. Microbiol. 2021, 203, 5621–5633. [Google Scholar] [CrossRef]
- Medema, M.H.; van Wezel, G.P. New solutions for antibiotic discovery: Prioritizing microbial biosynthetic space using ecology and machine learning. PloS Biol. 2025, 23, e3003058. [Google Scholar] [CrossRef]
- Zdouc, M.M.; van der Hooft, J.J.J.; Medema, M.H. Metabolome-guided genome mining of RiPP natural products. Trends Pharmacol. Sci. 2023, 44, 532–541. [Google Scholar] [CrossRef]
- Yang, Y. Screening and Discovery of Monoamine Oxidase Inhibitors in Marine Organisms. Master’s Thesis, Guangdong Ocean University, Zhanjiang, China, 2023. [Google Scholar]
- Yang, Y.; Zhou, L.J.; Liu, Y.Y.; Wang, Y.; Zhang, Y. Monoamine oxidase inhibition of butyrolactone I from marine Aspergillus terreus and virtual screening of its analogs. J. Zhanjiang Ocean Univ. 2023, 43, 119–128. [Google Scholar]
- Kazeem, M.I.; Abdulsalam, R.A.; Mellem, J.J.; Sabiu, S. Lemongrass (cymbopogon citratus) infusions exhibit neuroprotective properties: Evidence from in vitro and in silico studies. Food Biosci. 2025, 68, 106355. [Google Scholar] [CrossRef]
- Zhang, P.; Li, X.M.; Wang, J.N.; Li, X.; Wang, B.G. New butenolide derivatives from the marine-derived fungus Paecilomyces variotii with DPPH radical scavenging activity. Phytochem. Lett. 2015, 11, 85–88. [Google Scholar] [CrossRef]
- Qi, X.; Chen, W.H.; Lin, X.P.; Liao, S.R.; Yang, B.; Zhou, X.F.; Liu, Y.H.; Wang, J.F.; Li, Y. A glyoxylate-containing benzene derivative and butenolides from a marine algicolous fungus Aspergillus sp. SCSIO 41304. Nat. Prod. Res. 2023, 37, 441–448. [Google Scholar] [CrossRef] [PubMed]
- Ahn, S.; Jang, D.M.; Park, S.C.; An, S.; Shin, J.; Han, B.W.; Noh, M. Cyclin-dependent kinase 5 inhibitor butyrolactone I elicits a partial agonist activity of peroxisome proliferator-activated receptor γ. Biomolecules 2020, 10, 275. [Google Scholar] [CrossRef] [PubMed]
- Quintanilla, R.A.; Orellana, D.I.; González-Billault, C.; Maccioni, R.B. Interleukin-6 induces Alzheimer-type phosphorylation of tau protein by deregulating the cdk5/p35 pathway. Exp. Cell Res. 2004, 295, 245–257. [Google Scholar] [CrossRef] [PubMed]
- Niu, X.M.; Dahse, H.M.; Menzel, K.D.; Lozach, O.; Walther, G.; Meijer, L.; Grabley, S.; Sattler, I. Butyrolactone I derivatives from Aspergillus terreus carrying an unusual sulfate moiety. J. Nat. Prod. 2008, 71, 689–692. [Google Scholar] [CrossRef]
- Li, G.; Liu, T.; Kong, X.Q.; Wang, L.; Jin, X. Hippocampal glycogen synthase kinase 3β is critical for the antidepressant effect of cyclin-dependent kinase 5 inhibitor in rats. J. Mol. Neurosci. 2014, 54, 92–99. [Google Scholar] [CrossRef]
- Wang, X.Y.; Zhou, L.J.; Liu, Y.Y.; Ban, F.F.; Yang, Z.Y.; Zhang, Y.P.; Hu, X.Q.; Zhang, Y. Screening for anti-Aβ aggregation activity of marine fungal natural products based on a gold nanoparticle method. Chem. Biodivers. 2025, 22, e202401809. [Google Scholar] [CrossRef]
- Szandruk-Bender, M.; Wiatrak, B.; Szelag, A. The risk of developing Alzheimer’s disease and Parkinson’s disease in patients with inflammatory bowel disease: A meta-analysis. J. Clin. Med. 2022, 11, 3704. [Google Scholar] [CrossRef]
- Chen, S.W.; Niu, X.T.; Zhang, Y.; Wen, J.Y.; Bao, M.L.; Li, Y.; Gao, Y.; Wang, X.C.; Liu, X.X.; Yong, Y.H.; et al. Butyrolactone-I from marine fungi alleviates intestinal barrier damage caused by DSS through regulating lactobacillus johnsonii and its metabolites in the intestine of mice. J. Nutr. Biochem. 2025, 135, 109786. [Google Scholar] [CrossRef]
- Yang, F.; Zhou, L.; Deng, J.; Wang, Y.; Yang, Z.; Zhang, Y.; Liu, Y.; Zhang, Y. Marine fungal metabolite butyrolactone I improves Aβ1-42-induced cognitive impairment in mice via gut-brain axial microbiota remodeling, anti-inflammation, and antioxidation. J. Ocean. Limnol. 2025. [Google Scholar] [CrossRef]
- Dolga, A.M.; Granic, I.; Nijholt, I.M.; Nyakas, C.; van der Zee, E.A.; Luiten, P.G.M.; Eisel, U.L.M. Pretreatment with lovastatin prevents N-methyl-d-aspartate-induced neurodegeneration in the magnocellular nucleus basalis and behavioral dysfunction. J. Alzheimer’s Dis. 2009, 17, 327–336. [Google Scholar] [CrossRef]
- Frears, E.R.; Stephens, D.J.; Walters, C.E.; Davies, H.; Austen, B.M. The role of cholesterol in the biosynthesis of beta-amyloid. Neuroreport 1999, 10, 1699–1705. [Google Scholar] [CrossRef] [PubMed]
- Friedhoff, L.T.; Cullen, E.I.; Geoghagen, N.S.; Buxbaum, J.D. Treatment with controlled-release lovastatin decreases serum concentrations of human beta-amyloid (A beta) peptide. Int. J. Neuropsychopharmacol. 2001, 4, 127–130. [Google Scholar] [CrossRef] [PubMed]
- Darvesh, S.; Martin, E.; Walsh, R.; Rockwood, K. Differential effects of lipid-lowering agents on human cholinesterases. Clin. Biochem. 2004, 37, 42–49. [Google Scholar] [CrossRef] [PubMed]
- Roensch, J.; Crisby, M.; Nordberg, A.; Xiao, Y.; Zhang, L.J.; Guan, Z.Z. Effects of statins on α7 nicotine receptor, cholinesterase and α-form of secreted amyloid precursor peptide in SH-SY5Y. Neurochem. Int. 2007, 50, 800–806. [Google Scholar] [CrossRef]
- Mendoza-Oliva, A.; Ferrera, P.; Fragoso-Medina, J.; Arias, C. Lovastatin differentially affects neuronal cholesterol and amyloid- production invivo and invitro. CNS Neurosci. Ther. 2015, 21, 631–641. [Google Scholar] [CrossRef]
- Hosaka, A.; Araki, W.; Oda, A.; Tomidokoro, Y.; Tamaoka, A. Statins reduce amyloid β-peptide production by modulating amyloid precursor protein maturation and phosphorylation through a cholesterol-independent mechanism in cultured neurons. Neurochem. Res. 2013, 38, 589–600. [Google Scholar] [CrossRef]
- Lin, C.H.; Lin, H.I.; Chen, M.L.; Lai, T.T.; Cao, L.P.; Farrer, M.J.; Wu, R.M.; Chien, C.T. Lovastatin protects neurite degeneration in LRRK2-G2019S parkinsonism through activating the Akt/Nrf pathway and inhibiting GSK3β activity. Hum. Mol. Genet. 2016, 25, 1965–1978. [Google Scholar] [CrossRef]
- Martin, L.; Latypova, X.; Wilson, C.M.; Magnaudeix, A.; Perrin, M.L.; Yardin, C.; Terro, F. Tau protein kinases: Involvement in Alzheimer’s disease. Ageing Res. Rev. 2013, 12, 289–309. [Google Scholar] [CrossRef]
- Chen, J.W.; Luo, Y.L.; Hwang, M.J.; Peng, F.C.; Ling, K.H. Territrem B, a tremorgenic mycotoxin that inhibits acetylcholinesterase with a noncovalent yet irreversible binding mechanism. J. Biol. Chem. 1999, 274, 34916–34923. [Google Scholar] [CrossRef]
- Liu, Y.; Lin, L.Y.; Zheng, H.Y.; He, Y.L.; Li, Y.M.; Zhou, C.X.; Hong, P.Z.; Sun, S.L.; Zhang, Y.; Qian, Z.J. Mechanisms of antitumor invasion and metastasis of the marine fungal derivative epi-aszonalenin A in HT1080 cells. Mar. Drugs 2023, 21, 156. [Google Scholar] [CrossRef]

| Strain | Isolation Source | Depository Institution | Accession Number | GenBank Number |
|---|---|---|---|---|
| C21-11 | Porites pukoensis | GDMCC | GDMCC 62180 | JQ717316 |
| CD-17 | Holothuria scabra | Laboratory | GDOUMDI2021CD17 | OM319845.1 |
| C23-3 | Pavona cactus | GDMCC | GDMCC 60316 | MG707631.1 |
| No | Name | Structural Type (Method of Annotation) |
|---|---|---|
| 1 | 2,4-dihydroxy-5,6-dimethyl benzaldehyde | benzaldehyde (annotated by antiSMASH) |
| 2 | aspulvinone B1 | β,γ-type butenolide (annotated by antiSMASH) |
| 3 | aspulvinone H | β,γ-type butanolide (annotated by antiSMASH) |
| 4 | asterrelenin | benzodiazepine (annotated by antiSMASH) |
| 5 | epi-aszonalenin A | benzodiazepine (co-annotated by antiSMASH and GNPS) |
| 6 | butyrolactone I | α,γ-type butanolide (co-annotated by antiSMASH and GNPS) |
| 7 | butyrolactone III | α,γ-type butanolide (annotated by antiSMASH) |
| 8 | BTL-A | α,γ-type butanolide (annotated by GNPS) |
| 9 | BTL-B | α,γ-type butanolide (annotated by GNPS) |
| 10 | lovastatin | statin (co-annotated by antiSMASH and GNPS) |
| 11 | territrem B | meroterpenoid (annotated by GNPS) |
| 12 | donepezil | positive control of AChE |
| 13 | P_CDK5/p25 | positive control of CDK5/p25 |
| 14 | P_GSK-3β | positive control of GSK-3β |
| 15 | P_MAO-B | positive control of MAO-B |
Disclaimer/Publisher’s Note: The statements, opinions and data contained in all publications are solely those of the individual author(s) and contributor(s) and not of MDPI and/or the editor(s). MDPI and/or the editor(s) disclaim responsibility for any injury to people or property resulting from any ideas, methods, instructions or products referred to in the content. |
© 2025 by the authors. Licensee MDPI, Basel, Switzerland. This article is an open access article distributed under the terms and conditions of the Creative Commons Attribution (CC BY) license (https://creativecommons.org/licenses/by/4.0/).
Share and Cite
Ma, Z.; Zhou, L.; Yang, Z.; Liu, Y.; Zhang, Y. Exploring the Anti-Alzheimer’s Disease Potential of Aspergillus terreus C23-3 Through Genomic Insights, Metabolomic Analysis, and Molecular Docking. J. Fungi 2025, 11, 546. https://doi.org/10.3390/jof11080546
Ma Z, Zhou L, Yang Z, Liu Y, Zhang Y. Exploring the Anti-Alzheimer’s Disease Potential of Aspergillus terreus C23-3 Through Genomic Insights, Metabolomic Analysis, and Molecular Docking. Journal of Fungi. 2025; 11(8):546. https://doi.org/10.3390/jof11080546
Chicago/Turabian StyleMa, Zeyuan, Longjian Zhou, Zhiyou Yang, Yayue Liu, and Yi Zhang. 2025. "Exploring the Anti-Alzheimer’s Disease Potential of Aspergillus terreus C23-3 Through Genomic Insights, Metabolomic Analysis, and Molecular Docking" Journal of Fungi 11, no. 8: 546. https://doi.org/10.3390/jof11080546
APA StyleMa, Z., Zhou, L., Yang, Z., Liu, Y., & Zhang, Y. (2025). Exploring the Anti-Alzheimer’s Disease Potential of Aspergillus terreus C23-3 Through Genomic Insights, Metabolomic Analysis, and Molecular Docking. Journal of Fungi, 11(8), 546. https://doi.org/10.3390/jof11080546

